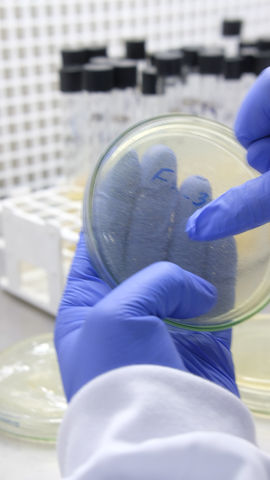

Welcome to a Great Coffee Experience!
15+ years of passion for green coffee excellence!
Creating innovative solutions for sustainable coffee production and trade.
We are not just any coffee company: our mission is to revolutionize the sector and create a fair economic model for the hard-working coffee growers of Colombia. Our belief in the value of human capital over financial capital has led us to reach unprecedented levels of competitiveness, quality and mutual cooperation.



Changing the game
We work with +18 exotic varieties of green coffee!
We ship green coffee to over 14 countries in the world!
We are in Colombia, Japan and Costa Rica!
Colors of Nature has created a Research Center for coffee processing called La Cereza in the south of Huila. There, our farmers experiment with different methods to process coffees of different varieties and altitudes, creating their own Naturals, Honeys and extended fermentations.
Since 2017, our coffee farmers, students and partners enjoy having the opportunity to learn in this unique facility in the world. If you want to discover more about our sustainable and exceptional quality coffee, click on:
Our OperationsTeam
Our operations team consists of five qualified and dedicated people who work tirelessly to ensure the smooth running of our company. Each of them brings their knowledge and experience to the team, contributing to the success of our operations.

The Sustainable Development Goals (SDGs) are a universal call to action to end poverty, protect the planet and improve the lives and prospects of people around the world. In 2015, all UN Member States adopted 17 Goals as part of the 2030 Agenda for Sustainable Development, which sets out a plan to achieve the Goals in 15 years.
Today we are proud to share that Colors Of Nature is a company that implements ALL of the Sustainable Development Goals. Demonstrating our commitment to protect the planet and the lives of all living beings in this universe.
*Disclaimer: Development goal No.14 "Life Below Water" does not classify in the activities that Colors Of Nature carries out, therefore it is not included in the image*.

.jpg)






